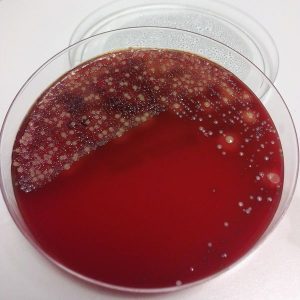

Labor Dr. Walder
Hygiene und medizinische Mikrobiologie | Infektiologie | Wasseranalytik | Tropenmedizin
Herzlich willkommen in unserem infektiologischen Labor in Außervillgraten – dem höchstgelegenen Labor Österreichs, wenn nicht sogar Europas.
Dr. Gernot Walder ist Facharzt für Hygiene und med. Mikrobiologie, Infektiologie und Tropenmedizin.
Das Labor ist DIN EN ISO 9001 zertifiziert und arbeitet nach allen aktuellen fachlichen Standards.
Unser Leistungsspektrum umfasst alle gängigen Standard- und Spezialuntersuchungen.
Wir freuen uns auf Sie und danken Ihnen für Ihr Vertrauen bereits im Voraus!
Ihr Team vom Labor Dr. Walder